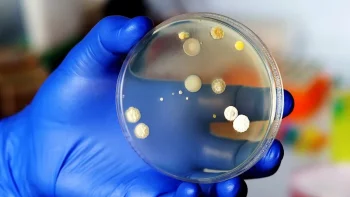

[OrtodoxInfo] 13/12/2025
[Mediafax] 13/12/2025
[HotNews] 13/12/2025
[Libertatea] 13/12/2025
[Europa FM] 13/12/2025
[Radio Iasi] 13/12/2025
[Financial Intelligence] 13/12/2025
[Ştirile ProTv] 13/12/2025
[G4Media] 13/12/2025
[StiripeSurse] 13/12/2025
[StiripeSurse] 13/12/2025
[Mediafax] 13/12/2025
[B1 Tv] 12/12/2025
[StiripeSurse] 12/12/2025
[Libertatea] 12/12/2025
[SpyNews] 12/12/2025
[Radio Iasi] 12/12/2025
[Observator] 12/12/2025
[HotNews] 12/12/2025
[SACCSIV - blog ortodox] 12/12/2025
[Observator] 12/12/2025
[Adevarul] 12/12/2025
[Cotidianul] 12/12/2025
[Realitatea] 12/12/2025
[Playtech] 12/12/2025
[Mediafax] 12/12/2025
[G4Media] 12/12/2025
[Jurnalul National] 12/12/2025
Prima ediție a Interior Design Week de la Iași are loc la Palas și promite o experiență captivantă, unde publicul larg poate găsi inspirația pentru modelarea unor spații de locuit în care să (…)
[Ieșeanul] 31/01/2024
Cu toții știm că directorul general interimar al CNIR, ieșeanul Cătălin Urtoi, are calități providențiale, ocupându-se de miracolul ctitoririi autostrăzilor Moldovei, dar iată că o întâmplare (…)
[Ieșeanul] 29/01/2024
Expozanți dedicați din toate colțurile țării se reunesc în Atriumul Palas pentru prima ediție din acest an a „Târgului de Artă și Antichități”. Bijuterii, argintărie, mic mobilier în diferite (…)
[Ieșeanul] 27/01/2024
După ce și-a petrecut Revelionul cu cea mai bună prietenă, ieșeanca Liliana Bordianu, Iulia Vântur a primit o nouă vizită din partea unei alte moldovence, Loredana Groza. Aceasta s-a aflat în (…)
[Ieșeanul] 26/01/2024
De dimineață m-am trezit cu o cugetare maximă în cap. Eu așa le zic gândurilor mele deștepte: cugetări maxime. Știu că o cugetare sau o maximă înseamnă cam același lucru, dar eu dintotdeauna am (…)
[Ieșeanul] 25/01/2024
Autoritatea Naţională pentru Protecţia Consumatorilor a aplicat, în săptămâna pe care o încheiem, peste 2.000 de amenzi, în valoare de aproape 15 milioane de lei, în urma controlelor efectate la (…)
[Radio Iasi] 13/12/2025
La Spitalul de Copii „Sfânta Maria” din Iași au fost sistate internările, după ce mai multe probe de apă prelevate de la unitatea medicală au ieşit necorespunzătoare pentru parametrul clor (…)
[Radio Iasi] 13/12/2025
Institutul Naţional Cantacuzino anunţă că a detectată şi la noi în ţară tulpina virusului gripal care circulă la nivel internaţional şi pentru care Centrul European de Prevenire şi Controlul (…)
[Radio Iasi] 13/12/2025
Ziua de joi, 11 decembrie 2025, a marcat unul dintre cele mai emoționante momente ale Galei „Awards for Excellence”, organizată la București de Confindustria România. În fața a sute de invitați, (…)
[Radio Iasi] 13/12/2025
UPDATE ora 23:00 – Președintele Consiliului Județean Iași, Costel Alexe, a transmis că, în urma dezinfecției rețelei de apă a Spitalului pentru Copii „Sf. Maria”, au fost prelevate și analizate (…)
[Radio Iasi] 12/12/2025
Peste 200 de reprezentanți de rang înalt ai instituțiilor statului român, oficiali ai autorităților centrale și locale, specialiști și experți din industria de apărare națională și internațională (…)
[Stirile Moldovei] 12/12/2025
Cozonacul rămâne simbolul incontestabil al sărbătorilor românești. În ciuda schimbărilor din comportamentul de consum și a creșterii ofertei de deserturi internaționale, românii rămân fideli (…)
[Stirile Moldovei] 11/12/2025
Ambasada României în Regatul Belgiei, în parteneriat cu Casa de Cultură a Studenților București, organizează luni, 15 decembrie 2025, începând cu ora 18:00, la sediul Secției Consulare a Ambasadei (…)
[Stirile Moldovei] 11/12/2025
O nouă mișcare strategică pentru NBI într-un moment în care piața rezidențială filtrează atent proiectele cu adevărat valoroase. North Bucharest Investments anunță includerea în portofoliul (…)
[Stirile Moldovei] 11/12/2025
North Bucharest Investments a închis luna noiembrie cu un volum tranzacționat cu aproape 15% mai mare față de luna octombrie, evoluție care marchează cea mai dinamică perioadă a ultimelor luni (…)
[Stirile Moldovei] 10/12/2025
Ziare Moldova
Evenimentul
.
Literatura și Arta
.
Stirile Moldovei
Ziar.com indexează publicații diverse, ziare și reviste cu poziții diferite, existente independent online. Ideile și comentariile exprimate în aceste articole nu reflectează opiniile Ziar.com și nu pot fi imputate acestuia. Pentru orice informație complementară sau reclamație cu privire la conținut, consultați direct ziarele relevante – sursa este întotdeauna indicată, cu un link spre articolul de origină.
Publicare, realizare si gazduire web : DIRECTWAY. Toate drepturile rezervate, reproducerea interzisa - Copyright © 1996-2025 DIRECTWAY